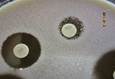
Obr�zek24
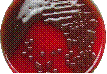

Oddělení
lékařské mikrobiologie







Laboratorní příručka
verze 07 / 2024
Seznam kapitol Laboratorní
příručky OLM

Oddělení
lékařské mikrobiologie

Laboratorní příručka
verze 07 / 2024
Seznam kapitol Laboratorní
příručky OLM